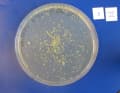
A nutrient medium is applied to so-called agar plates. The bacteria feed on this and then grow into colonies (yellow dots).
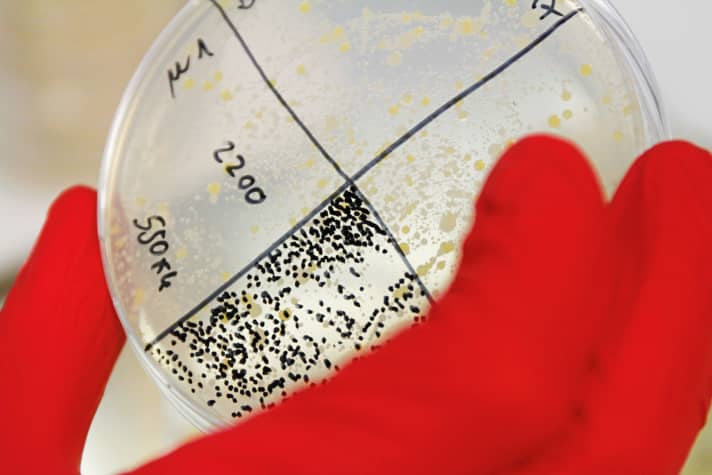
A whole carpet of bacteria has spread on the sample of the brand-new merino shirt. We counted 550 colonies in the lower quarter of the sample alone. It is unlikely that they all come from skin bacteria.

In this article, we use so-called affiliate links. With every purchase through these links, we receive a commission from the merchant. All relevant referral links are marked with . Learn more.
Silver ions, merino wool fibres, washing additives and tried-and-tested household remedies - the clothing industry knows many ways to defuse unpleasant odours in sportswear. But what really works and where does the pungent odour in worn bike shirts and vests actually come from?
Read the article:
- The sweat killers Merino & Co. in the lab test
- These bacteria are responsible for the odour
- What are silver ions and merino wool good for?
- Baking soda, freezing and more - do the methods deliver what they promise?
- Preventing odours - 5 tricks against stink
- Interview with Guido Augustiniak, Managing Director of Fibertec
To get to the bottom of the mysterious sweat odour, we carried out extensive laboratory tests. The experts at the Microbiology specialists Vermicon were on hand with help and advice. The basic finding of our experiment: fresh sweat doesn't stink. The stench is caused by bacteria that occur naturally on human skin. More precisely, they are two representatives of the Firmicutes and Actinobacteria species. They metabolise the sweat molecules in cycling clothing and then excrete smelly gases.

Sportswear: the sweat killers Merino & Co. put to the test
For our test, we were looking for materials and products to prevent odour build-up. Underwear with silver ions has been one of the most popular odour inhibitors for sportswear on the market for many years. The antimicrobial finish is designed to change the cell structure of bacteria and thus prevent their growth. The natural counterpart to this: Merino wool. Merino sheep's wool has a reputation for having an odour-inhibiting effect. However, little is known about its exact mode of action.
In order to find out whether the products really work as the manufacturers promise, we got ourselves two copies each of a silver and a merino shirt. One vest was worn brand new and then sent to the laboratory, the other two were first washed ten times, then worn and then sent for testing. Of course, we also wanted to know how durable the anti-stink effects are.
In another test, a classic polyester shirt was worn and sent to the laboratory. Samples were taken from this shirt and then treated in different ways. We tested how residue-free sports detergent, hygiene rinse aid and washing soda (baking soda) remove the bacteria - the source of the odour - from the laundry. We also scrutinised an old household myth using the "freezer method" - with surprising results.




Analysing bacteria under the microscope
When testing samples for odour bacteria, the experts at Vermicon use a unique technology called VIT gene probe technology. Gene probes are added to the samples of cycle clothing via a solution. These gene probes consist of an RNA strand to which a dye is attached. The gene probes penetrate the bacteria and attach themselves to the bacteria's RNA according to the lock-and-key principle. Of course, this only works if the gene probe matches the bacteria's RNA. The dye molecules are now trapped in the bacterial cell. If the samples are then placed under the microscope, the cells begin to glow. Firmicutes or actinobacteria can thus be specifically detected in the substances.

To determine how many bacteria grow in the samples, the odour-causing agents are removed from the shirts and a defined quantity is applied to a culture medium. After two days at 37 degrees in the incubator, the bacterial colonies on the culture medium are counted. Using these two methods, a clear statement can be made about the presence of bacteria.

After the lab test, Claudia Beimfohr calls us in to analyse the results. The result surprises even the researcher: the bacterial colonies on the samples of the two brand-new shirts crowd together like groupies at a pop concert. A count is hardly possible. The expert puzzles that this cannot be due to the sporting activity alone. She suspects that the functional shirts could come into contact with bacteria during production, packaging and transport. Even if these are harmless species, Beimfohr expressly advises against this, wash a new item thoroughly before wearing it for the first time. A different picture emerges on the culture media of the shirts that have been washed ten times. The bacterial counts are more like the picture of the inauguration of the new American president in front of the Capitol. There is still a relatively large amount of free space in the bowls. The result reinforces our first hypothesis, but raises further questions. Why are there still clearly detectable colonies of stink bacteria growing on the shirt with the silver finish? The manufacturer at least promises that the microbes should not continue to multiply after coming into contact with silver.
The biggest stinkers: these bacteria cause unpleasant odours in cycling clothing
Sweat itself is odourless. Bacteria are responsible for the odour in cycling clothing. We were able to identify two specimens as the main culprits.
Staphylococci
Spherical cells with a size of 0.5 to 1.5 μm, which occur in grape-like clusters as skin bacteria. Their optimum temperature is between 30 and 37 degrees. The staphylococcus species that occur on human skin and mucous membranes are generally not pathogenic and are harmless.

Corynebacterium
These club-shaped (Greek coryne = club) bacteria are between 3 and 5 μm long. Certain members of the genus can cause diphtheria when infected by bacteriophages. However, the representatives found on human skin and mucous membranes are generally not pathogenic.

Incidentally, the germ-killing effect of silver was already known in ancient times. Today, microsilver is used in deodorants, cosmetics and, above all, in functional clothing. The silver ions penetrate the bacteria, change their cell metabolism and thus stop them from multiplying. However, their use is controversial. In a test, the Gothenburg environmental authority analysed newly purchased garments that had been washed ten times. The result: all textiles release silver ions in the wash, which can then enter the water cycle. Research results from the Hohenstein Institute at least suggest that the silver ions do not harm the natural skin flora, but here too other studies have produced contradictory results. The benefits of the silver finish for sports use appear to be limited to the Vermicon researchers. Obviously, the product does not manage to "neutralise" all bacteria. Beimfohr concludes from the results that the equipment can therefore be dispensed with.
The effectiveness of merino wool cannot be proven with certainty in our laboratory test either. Bacterial colonies also grow on the sample of the shirt that has been washed ten times. The effect of merino wool lies more in its fibre structure. The Hohenstein scientists made an exciting discovery in this regard: wool binds odour molecules more strongly and for longer than polyester, for example - and therefore only starts to stink later. The molecules responsible for the odour can apparently be released more easily from synthetic fibres and penetrate our noses.
Whichever product you ultimately choose for your sportswear: The clothing material alone or an antimicrobial finish, such as silver ions or merino, will not get rid of the stink bugs.
Silver vs. merino against unpleasant odours
Natural fibres or chemical mace - manufacturers take different approaches to prevent annoying sweat odours in functional clothing. However, the aim remains the same: to prevent the bacteria from decomposing the sweat. This is how the two approaches work.
Silver ions
There are two methods of bonding the nano-silver particles to the fibre. Either the nano-silver is mixed into a polymer and then spun into fibres, or it is applied to the fibre surface as a finish afterwards. The former results in a particularly strong bond with the fibre. The antimicrobial effect of nanosilver is utilised in both applications. The release of silver ions (Ag+) kills bacteria when the clothing is worn. The silver ions penetrate the bacteria, change their cell metabolism and can thus stop them from multiplying.
Merino fibre
The surface structure of the fibres works like roof tiles. Bacteria find little support there and therefore remain mainly on the skin. Because merino wool absorbs a lot of moisture quickly, the bacteria have little time to decompose the sweat. The basic building block of merino wool is the protein molecule creatine. The special thing about it is that these molecules make it particularly difficult for bacteria to multiply. The decomposition process of sweat is thus naturally delayed and the unpleasant odour only develops much later (this is referred to as a self-cleaning function) than with synthetic fibres.
The bacteria killers - this helps against smelly sportswear
Special detergent, chemicals or cold shock. We wanted to know which method removes bacteria from clothing most effectively. However, we still have our detergent samples up our sleeve. And beware: compared to the first four samples, the test discs of the washing additives are as empty as the streets on New Year's morning. Even in the 40-degree wash, hygiene rinse aid, sports detergent and washing soda dissolve almost all bacteria from the textile samples. So washing helps! Nevertheless, washing at low temperatures with normal detergent is not always enough to kill germs, warns the expert from the Hohenstein Institute. Depending on the fabric, an unpleasant odour can also settle in the cycling clothing. This is one reason why older functional shirts often smell rancid as soon as you slip them on. Dr Beimfohr advises that occasionally risking a 60-degree wash could help here and in the same breath destroys an old household myth: freezing is a good idea, smiles the researcher. As soon as the bacteria have woken up from their hibernation, they continue to feed and produce their foul-smelling odours.
If climate change continues to progress so rapidly and heat up the earth, it will soon be impossible to walk past some lockers in the BIKE cellar without risking fainting. By then, however, even the last colleague will have to admit it: It's true, we really do have a sweat problem.

Before washing, numerous bacterial colonies (yellow) grow on the polyester shirt. We subjected samples from this textile to four different applications. At the end, no more bacteria should grow on the culture medium.

Hygienic dishwasher
Sagrotan is the most effective agent against bacteria in our comparison. In the test, the sanitiser removed all microbes almost completely. It acts like a disinfectant, breaking down the cell walls and thus destroying the bacterial cells. However, it is still questionable whether and how harmful Sagrotan is for the fibres of functional clothing and as a residue in waste water.

Sports detergent
In the test, the Textile Wash from Holmenkol similar to Sagrotan. Due to the substances it contains, the sports detergent acts like a chlorine-vinegar treatment, i.e. similar to an acid bath, in which the bacteria are killed. Only slight bacterial residues are visible on the agar plate (culture medium), recognisable by the two yellow dots at the edge of the sample.

Washing soda
Dissolved in water is Washing soda strongly alkaline and also dissolves stubborn dirt and grease. In the test, Holste's product showed a good but lower effect compared to the other two detergents. Some bacterial cultures can still be detected on the culture medium. Incidentally, soda is not suitable for textiles made from animal fibres, as it causes the fibres to swell.

Freezing sportswear
This popular household remedy is a myth. The bacteria virtually go into hibernation at -20 degrees. As soon as the temperature rises again and nutrients are available, the bacteria resume their work and metabolise the sweat. Presumably, some bacteria also die because their cell walls are destroyed. However, the majority survive. In addition, the bacteria remain in the fabric of the sportswear because they are not mechanically washed out of the fibre as with the other methods.

Never stink again? These tricks prevent odours from developing in your cycling clothing in the first place
Even if the advertising promises it, there are still no absolutely odour-resistant functional textiles. Nevertheless, we have a few tips on how you can dilute the thick air in your locker and reduce odours in your cycling clothing.
1. dry jerseys
Hang your cycling clothing up to dry immediately after your ride. Skin bacteria love warm and humid conditions and thrive particularly well in these conditions. So if you leave your clothes lying damp in a pile, the odour is practically pre-programmed. Cold also helps. Bacteria only work at full speed at their optimum temperature. However, this only delays the growth of bacteria.
2. wash after every ride
Sportswear made of synthetic fibres in particular should be washed after each wear. If you put a previously worn item back on for the next outing, the bacteria will literally be served their food on a silver platter and can continue to decompose the sweat molecules already present.
3. wash at risk
Skin bacteria are heat-resistant and cannot be destroyed at 40 degrees. Even if the care label only allows washing at 40 degrees, Craft recommends washing at 60 degrees every third time, for example. Exception: Items with elastane content must not be boil-washed because these fibres shrink when exposed to heat, destroying the garment. The alternative: There is cycling clothing that can be washed at 60 degrees. So always check the instructions on the label when buying.

4. shave
The warm and humid climate under the armpits is a cosy oasis for skin bacteria. They sit there on the underarm hair like chickens on a roost. If you shave, you will not go through life without bacteria, which is not what you want. However, the tiny sweat-eaters will find it much harder to make themselves comfortable because there is simply less space available.
5. exchange regularly
Everyone knows the problem: there comes a time when your vest starts to smell just by putting it on. Odour molecules can become very stubbornly embedded in the textile fibres, meaning that they cannot be completely removed even in the washing machine. Over time, more and more of these odour molecules accumulate in the garment and create a permanent unpleasant smell. There is only one thing to do now: the old item must be discarded and replaced with a new one.
Interview with Guido Augustiniak, Managing Director of Fibertec
Fibertec is a manufacturer of impregnation and care products, Managing Director Guido Augustiniak told us in an interview:
Activated carbon fibres made from coconut shells would be an ideal alternative to chemical finishes - Guido Augustiniak, Managing Director of Fibertec
BIKE: Why do you advise against using silver additives in clothing and washing additives?
Guido Augustiniak: Silver ions work great in themselves. Unfortunately, they do not differentiate between "good" and "bad" bacteria. They simply kill all bacteria on contact and can therefore disrupt our sensitive skin flora, which is an important part of our immune system.
Are there any other problems?
The silver ions get into the waste water via the laundry and thus into the sewage treatment plants. There they also destroy the bacteria that are actually supposed to purify our water, for example from faeces. As a result, there is a risk that resistant strains of bacteria will develop. This phenomenon already exists with antibiotics, which is already causing problems in hospitals today.
What are the alternatives?
We are working on a detergent that works at enzyme level and triggers a biological reaction. The effect is based on van der Waals forces and converts smelly substances into odourless salts. We are already using this in a shoe deodorant.
What alternatives are already available today?
Natural fibres such as merino wool, for example. They don't have such a strong odour by nature. Unfortunately, merino underwear is less suitable for intensive activities because it absorbs a lot of sweat. There are also functional underwear that can be washed at 60 degrees. This kills the bacteria during washing and you can safely do without chemical additives or finishes. Sweat itself doesn't stink. The odour only arises when the bacteria decompose the sweat.
So why do I need detergent at all?
A good, ecological detergent is the basis. It not only removes dirt, but also odour-causing bacteria. Incidentally, I do not recommend using sanitisers such as Sagrotan. They are just as aggressive as silver ions and kill all bacteria unspecifically.
Are there other natural fibres besides merino?
Yes, the so-called Cocona fibre is based on activated carbon from recycled coconut shells. The great thing about it is that, unlike merino wool, the fibre dries just as quickly as synthetic fibres. Despite this, the laundry does not smell unpleasant even after repeated wear. Unfortunately, the fibre is currently only used by very few manufacturers. It would be a great alternative for athletes who sweat a lot at high intensity.


Stefan Frey
Editor
